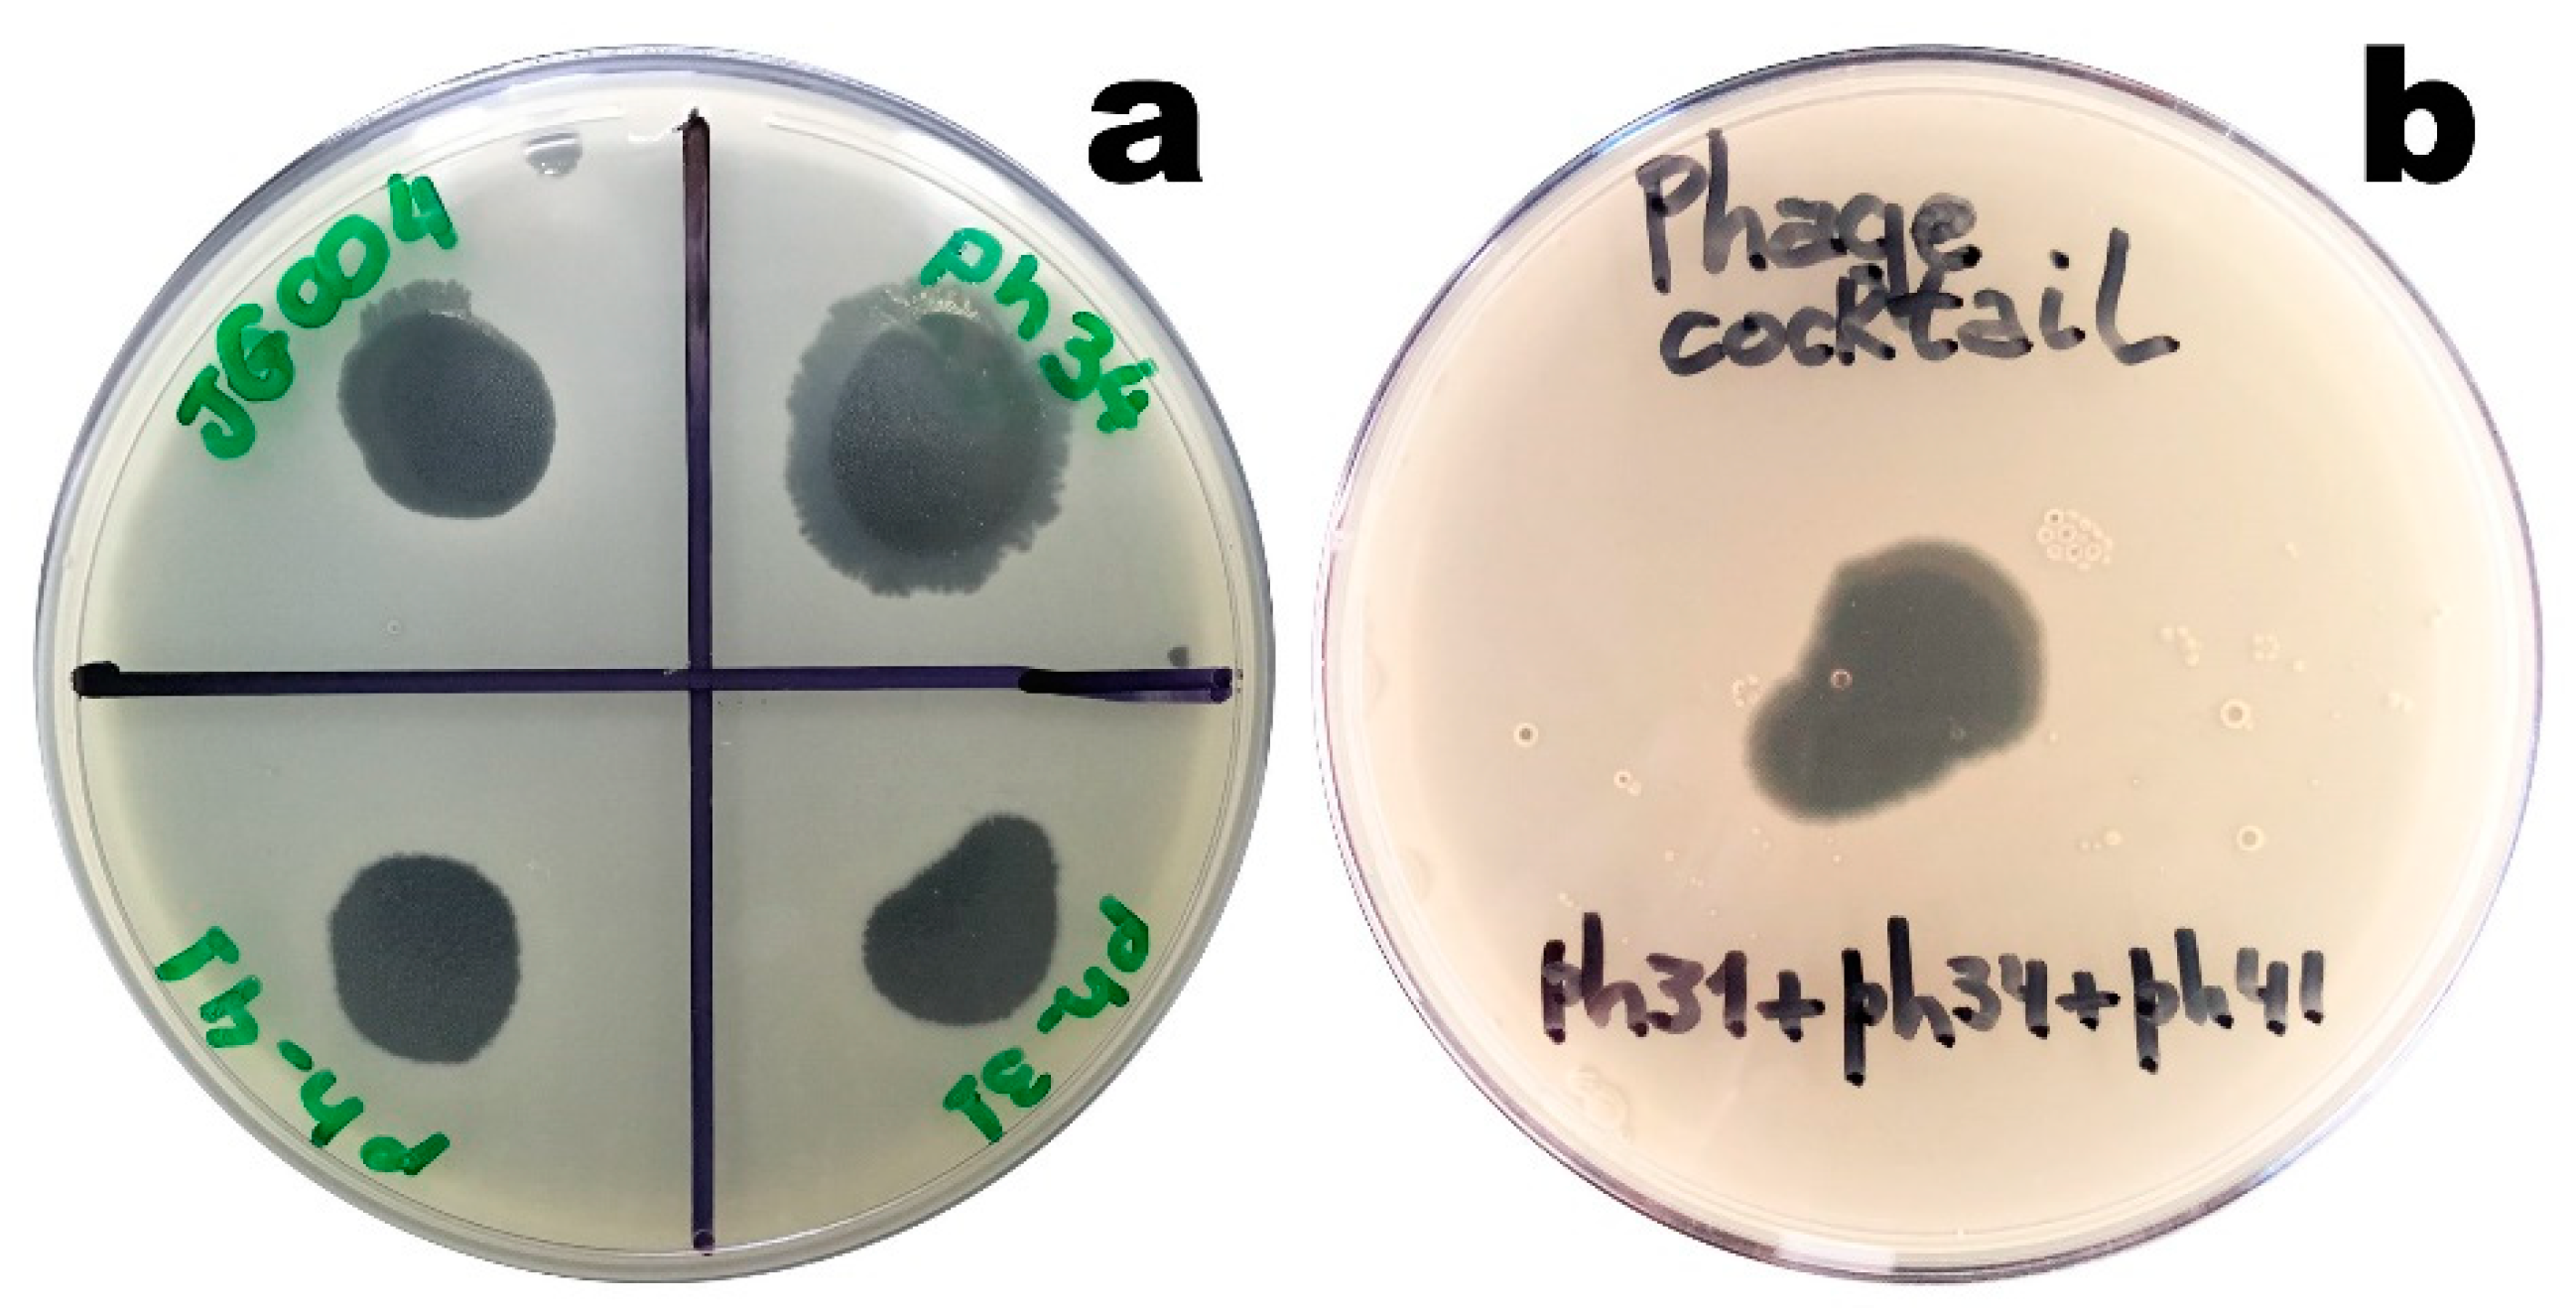
Biosensors 11 00124 g003 Biosensors 11 00124 g003

Bacteriophage-Based Biosensing of Pseudomonas aeruginosa: An Integrated Approach for the Putative Real-Time Detection of Multi-Drug-Resistant Strains
Abstract
1. Introduction
2. Materials and Methods
2.1. Materials
2.1.1. Biological Materials
Bacteria
Phages
2.1.2. Chemicals
2.2. Experimental Procedures
2.2.1. Bacterial Strain and Growth Conditions
2.2.2. Preparation of P. aeruginosa Bacterial Lawns
2.2.3. Gelification/Polymerization Conditions for Producing Sodium Alginate-Based Matrices
2.2.4. Evaluation of the Maintenance of Lytic Viability of the Immobilized Phage Particles
2.2.5. Tomographic Analyses via X-ray Transmission
2.2.6. Scanning Electron Microscopy Analyses
2.2.7. Phage-Based Bacterial Biosensing Trials Using Bio-Detection System I
2.2.8. Phage-Based Bacterial Biosensing Trials Using a Bio-Detection System II
3. Results
3.1. Lytic Activity of the Isolated Phages
3.2. Evaluation of the Structural and Functional Stabilization of the Immobilized Phage Particles
3.3. Structural Microanalysis of the Bioluminescent/Chromogenic Hydrogel
3.4. Tomographic Analyses
3.5. Phage-Based Bacterial Biosensing Trials Using Biodetection System I
3.6. Phage-Based Bacterial Biosensing Trials Using Biodetection System II
4. Discussion
5. Conclusions
Author Contributions
Funding
Institutional Review Board Statement
Informed Consent Statement
Data Availability Statement
Acknowledgments
Conflicts of Interest
References
- Harada, L.K.; Silva, E.C.; Campos, W.F.; Del Fiol, F.S.; Vila, M.M.D.C.; Dąbrowska, K.; Krylov, V.N.; Balcão, V.M. Biotechnological applications of bacteriophages: State of the art. Microbiol. Res. 2018, 38–58. [Google Scholar] [CrossRef] [PubMed]
- Rios, A.C.; Vila, M.M.D.C.; Lima, R.; Del Fiol, F.S.; Tubino, M.; Teixeira, J.A.; Balcão, V.M. Structural and functional stabilization of bacteriophage particles within the aqueous core of a W/O/W multiple emulsion: A potential biotherapeutic system for the inhalational treatment of bacterial pneumonia. Process Biochem. 2018, 64, 177–192. [Google Scholar] [CrossRef]
- Caselli, D.; Cesaro, S.; Ziino, O.; Zanazzo, G.; Manicone, R.; Livadiotti, S.; Cellini, M.; Frenos, S.; Milano, G.M.; Cappelli, B.; et al. Multidrug resistant Pseudomonas aeruginosa infection in children undergoing chemotherapy and hematopoietic stem cell transplantation. Haematologica 2010, 95, 1612–1615. [Google Scholar] [CrossRef] [PubMed]
- Neves, M.T.; Lorenzo, M.E.P.; Almeida, R.A.M.B.; Fortaleza, C.M.C.B. Antimicrobial use and incidence of multidrug-resistant Pseudomonas aeruginosa in a teaching hospital: An ecological approach. Rev. Soc. Bras. Med. Trop. 2010, 43, 629–632. [Google Scholar] [CrossRef][Green Version]
- Chan, B.K.; Abedon, S.T.; Loc-Carrillo, C. Phage cocktails and the future of phage therapy. Future Microbiol. 2013, 8, 769–783. [Google Scholar] [CrossRef] [PubMed]
- Haq, I.U.; Chaudhry, W.N.; Akhtar, M.N.; Andleeb, S.; Qadri, I. Bacteriophages and their implications on future biotechnology: A review. Virol. J. 2012, 9, 2–8. [Google Scholar] [CrossRef] [PubMed]
- Balcão, V.M.; Moreira, A.R.; Moutinho, C.G.; Chaud, M.V.; Tubino, M.; Vila, M.M.D.C. Structural and functional stabilization of phage particles in carbohydrate matrices for bacterial biosensing. Enzym. Microb. Technol. 2013, 53, 55–69. [Google Scholar] [CrossRef]
- Balcão, V.M.; Barreira, S.V.P.; Nunes, T.M.; Chaud, M.V.; Tubino, M.; Vila, M.M.D.C. Carbohydrate hydrogels with stabilized phage particles for bacterial biosensing: Bacterium diffusion studies. Appl. Biochem. Biotechnol. 2014, 172, 1194–1214. [Google Scholar] [CrossRef]
- Balcão, V.M.; Glasser, C.A.; Chaud, M.V.; del Fiol, F.S.; Tubino, M.; Vila, M.M.D.C. Biomimetic aqueous-core lipid nanoballoons integrating a multiple emulsion formulation: A suitable housing system for viable lytic bacteriophages. Colloids Surf. B Biointerfaces 2014, 123, 478–485. [Google Scholar] [CrossRef] [PubMed]
- Puapermpoonsiri, U.; Spencer, J.; van der Walle, C.F. A freeze-dried formulation of bacteriophage encapsulated in biodegradable microspheres. Eur. J. Pharm. Biopharm. 2009, 72, 26–33. [Google Scholar] [CrossRef]
- Sulakvelidze, A.; Kutter, E. Bacteriophage therapy in humans. In Bacteriophages: Biology and Applications; Kutter, E., Sulakvelidze, A., Eds.; CRC Press: Boca Raton, FL, USA, 2005; pp. 381–436. [Google Scholar]
- Sulakvelidze, A.; Alavidze, Z.; Morris, J.G., Jr. Bacteriophage therapy. Antimicrob. Agents Chemother. 2001, 45, 649–659. [Google Scholar] [CrossRef]
- Hanlon, G.W. Bacteriophages: An appraisal of their role in the treatment of bacterial infections. Int. J. Antimicrob. Agents 2007, 30, 118–128. [Google Scholar] [CrossRef] [PubMed]
- Abedon, S.T. The Bacteriophages, 2nd ed.; Oxford University Press: Oxford, UK, 2006. [Google Scholar]
- Chibani-Chennoufi, S.; Bruttin, A.; Dillmann, M.L.; Brüssow, H. Phage-host interaction: An ecological perspective. J. Bacteriol. 2004, 186, 3677–3686. [Google Scholar] [CrossRef] [PubMed]
- Rohwer, F. Global phage diversity. Cell 2003, 113, 141. [Google Scholar] [CrossRef]
- Hatfull, G.F.; Hendrix, R.W. Bacteriophages and their genomes. Curr. Opin. Virol. 2011, 1, 298–303. [Google Scholar] [CrossRef] [PubMed]
- Pope, W.H.; Hatfull, G.F. Adding pieces to the puzzle: New insights into bacteriophage diversity from integrated research-education programs. Bacteriophage 2015, 5, e1084073. [Google Scholar] [CrossRef]
- Hwang, W.; Yoon, S.S. Virulence Characteristics and an Action Mode of Antibiotic Resistance in Multidrug-Resistant Pseudomonas aeruginosa. Sci. Rep. 2019, 9, 1–15. [Google Scholar] [CrossRef]
- Ribeiro, Á.C.S.; Crozatti, M.T.L.; Silva, A.A.; Macedo, R.S.; Machado, A.M.O.; Silva, A.T.A. Pseudomonas aeruginosa in the ICU: Prevalence, resistance profile, and antimicrobial consumption. J. Braz. Soc. Trop. Med. 2020, 53, 1–6. [Google Scholar] [CrossRef]
- Abadi, A.T.B.; Rizvanov, A.A.; Haertlé, T.; Blatt, N.L. World Health Organization Report: Current Crisis of Antibiotic Resistance. Bionanoscience 2019, 9, 778–788. [Google Scholar] [CrossRef]
- Schmelcher, M.; Loessner, M.J. Bacteriophage: Powerful tools for the detection of bacterial pathogens. In Principles of Bacterial Detection: Biosensors, Recognition Receptors and Microsystems; Zourob, M., Elwary, S., Turner, A.P.F., Eds.; Springer: Berlin/Heidelberg, Germany, 2008; pp. 727–750. [Google Scholar]
- Schmelcher, M.; Loessner, M.J. Application of bacteriophages for detection of foodborne pathogens. Bacteriophage 2014, 4, e28137. [Google Scholar] [CrossRef]
- Smartt, A.E.; Ripp, S. Bacteriophage reporter technology for sensing and detecting microbial targets. Anal. Bioanal. Chem. 2011, 400, 991–1007. [Google Scholar] [CrossRef]
- Smietana, M.; Bock, W.J.; Mikulic, P.; Ng, A.; Chinnappan, R.; Zourob, M. Detection of bacteria using bacteriophages as recognition elements immobilized on long-period fiber gratings. Opt. Express 2011, 19, 7971–7978. [Google Scholar] [CrossRef]
- Weinstein, M.P.; Mirrett, S.; Reller, L.B. Comparative evaluation of Oxoid Signal and BACTEC radiometric blood culture systems for the detection of bacteremia and fungemia. J. Clin. Microbiol. 1988, 26, 962–964. [Google Scholar] [CrossRef] [PubMed]
- Pheiffer, C.; Carroll, N.M.; Beyers, N.; Donald, P.; Duncan, K.; Uys, P.; van Helden, P. Time to detection of Mycobacterium tuberculosis in BACTEC systems as a viable alternative to colony counting. Int. J. Tuberc. Lung Dis. 2008, 12, 792–798. [Google Scholar]
- Rees, C.E.D.; Loessner, M.J. Phage for the detection of pathogenic bacteria. In Bacteriophages: Biology and Applications; Sulakvelidze, E.K.A., Ed.; CRC Press: Boca Raton, FL, USA, 2005; pp. 267–285. [Google Scholar]
- Rees, C.E.; Dodd, C.E. Phage for rapid detection and control of bacterial pathogens in food. Adv. Appl. Microbiol. 2006, 59, 159–186. [Google Scholar] [PubMed]
- Mole, R.J.; Maskell, T.W.O. Phage as a diagnostic—The use of phage in TB diagnosis. J. Chem. Technol. Biotechnol. 2001, 76, 683–688. [Google Scholar] [CrossRef]
- Pai, M.; Kalantri, S.P. Bacteriophage-based tests for tuberculosis. Indian J. Med. Microbiol. 2005, 23, 149–150. [Google Scholar] [CrossRef] [PubMed]
- Hagens, S.; Loessner, M.J. Application of bacteriophages for detection and control of foodborne pathogens. Appl. Microbiol. Biotechnol. 2007, 76, 513–519. [Google Scholar] [CrossRef]
- Ripp, S. Bacteriophage-based pathogen detection. Adv. Biochem. Eng. Biotechnol. 2010, 118, 65–83. [Google Scholar] [PubMed]
- Heo, J.; Hua, S.Z. An overview of recent strategies in pathogen sensing. Sensors 2009, 9, 4483–4502. [Google Scholar] [CrossRef]
- Capek, P.; Kirkconnell, K.S.; Dickerson, T.J. A Bacteriophage-based platform for rapid trace detection of proteases. J. Am. Chem. Soc. 2010, 132, 13126–13128. [Google Scholar] [CrossRef][Green Version]
- Carlson, K. Working with bacteriophages: Common techniques and methodological approaches. In Bacteriophages Biology and Applications; Kutter, E., Sulakvelidze, A., Eds.; CRC Press: Boca Raton, FL, USA, 2004; pp. 437–494. [Google Scholar]
- Pinheiro, L.A.M.; Pereira, C.; Frazão, C.; Balcão, V.M.; Almeida, A. Efficiency of Phage φ6 for Biocontrol of Pseudomonas syringae pv. syringae: An in Vitro Preliminary Study. Microorganisms 2019, 7, 286. [Google Scholar] [CrossRef]
- Pinheiro, L.A.M.; Pereira, C.; Barreal, M.E.; Gallego, P.P.; Balcão, V.M.; Almeida, A. Use of phage ϕ6 to inactivate Pseudomonas syringae pv. actinidiae in kiwifruit plants: In vitro and ex vivo experiments. Appl. Microbiol. Biotechnol. 2019, 104, 1319–1330. [Google Scholar] [CrossRef]
- Shinomiya, T.; Shiga, S. Bactericidal activity of the tail of Pseudomonas aeruginosa bacteriophagePS17. J. Virol. 1979, 32, 958–967. [Google Scholar] [CrossRef]
- Markoishvili, K.; Tsitlanadze, G.; Katsarava, R.; Glenn, J.; Sulakvelidze, A. A novel sustained-release matrix based on biodegradable poly(ester amide)s and impregnated with bacteriophages and an antibiotic shows promise in management of infected venous stasis ulcers and other poorly healing wounds. Int. J. Dermatol. 2002, 41, 453–458. [Google Scholar] [CrossRef]
- Petty, N.K.; Evans, T.J.; Fineran, P.C.; Salmond, G.P.C. Biotechnological exploitation of bacteriophage research. Trends Biotechnol. 2006, 25, 7–15. [Google Scholar] [CrossRef]
- McNerney, R.; Mallard, K.; Urassa, H.M.R.; Lemma, E.; Donoghue, H.D. Colorimetric phage-based assay for detection of rifampin-resistant Mycobacterium tuberculosis. J. Clin. Microb. 2007, 45, 1330–1332. [Google Scholar] [CrossRef][Green Version]
- Azzazy, H.M.E.; Highsmith, W.E., Jr. Phage display technology: Clinical applications and recent innovations. Clin. Biochem. 2002, 35, 425–445. [Google Scholar] [CrossRef]
- Mosier-Boss, P.A.; Lieberman, S.H.; Andrews, J.M.; Rohwer, F.L.; Wegley, L.E.; Breitbart, M. Use of fluorescently labeled phage in the detection and identification of bacterial species. Appl. Spectrosc. 2003, 57, 1138–1144. [Google Scholar] [CrossRef]
- Ashida, A.; Yamada, Y.; Kamidate, T. Colorimetric method for enzymatic screening assay of ATP using Fe(III)-xylenol orange complex formation. Anal. Bioanal. Chem. 2008, 392, 987–994. [Google Scholar] [CrossRef]
- Park, J.K.; Chang, H.N. Microencapsulation of microbial cells. Biotechnol. Adv. 2000, 18, 303–319. [Google Scholar] [CrossRef]
- Covizzi, L.G.; Giese, E.C.; Gomes, E.; Dekker, R.; Silva, R. Imobilização de células microbianas e suas aplicações biotecnológicas. Ciências Exatas Tecnológicas 2007, 28, 143–160. [Google Scholar] [CrossRef]
- Moutinho, C.G.; Matos, C.M.; Teixeira, J.A.; Balcão, V.M. Nanocarrier possibilities for functional targeting of bioactive peptides and proteins: State-of-the-art. J. Drug Target. 2012, 20, 114–141. [Google Scholar] [CrossRef] [PubMed]
- Souza, G.R.; Christianson, D.R.; Staquicini, F.I.; Ozawa, M.G.; Snyder, E.Y.; Sidman, R.L.; Miller, J.H.; Arap, W.; Pasqualini, R. Networks of gold nanoparticles and bacteriophage as biological sensors and cell-targeting agents. Proc. Natl. Acad. Sci. USA 2006, 103, 1215–1220. [Google Scholar] [CrossRef]
- Draget, K.I.; Moe, S.T.; Skjak-Bræk, G.; Smidsrod, O. Alginates. In Food Polysaccharides and Their Applications; Stephen, A.M., Phillips, G.O., Williams, P.A., Eds.; Taylor & Francis Group: New York, NY, USA, 2006; pp. 289–334. [Google Scholar]
- Donati, I.; Paoletti, S. Material Properties of Alginates. In Alginates: Biology and Applications; Rehm, B.H.A., Ed.; Springer: Münster, Germany, 2009; pp. 1–53. [Google Scholar]
- Oliveira, J.M.; Martins, A.C.G. Construction and test of low cost X-ray tomography scanner for physical-chemical analysis and nondestructive inspections. AIP Conf. Proc. 2009, 1139, 102–105. [Google Scholar]
- Feldkamp, L.A.; Davis, L.C.; Kress, J.W. Practical cone-beam algorithm. J. Opt. Soc. Am. A 1984, 1, 612–619. [Google Scholar] [CrossRef]
- Ahmed, A.; Rushworth, J.V.; Hirst, N.A.; Millner, P.A. Biosensors for whole-cell bacterial detection. Clin. Microbiol. Rev. 2014, 27, 631–646. [Google Scholar] [CrossRef]
- Zourob, M.; Ripp, S. Bacteriophage-Based Biosensors. In Recognition Receptors in Biosensors; Zourob, M., Ed.; Springer: Berlin/Heidelberg, Germany, 2010; pp. 415–448. [Google Scholar]
- Mirzaei, M.K.; Nilsson, A.S. Isolation of phages for phage therapy: A comparison of spot tests and efficiency of plating analyses for determination of host range and efficacy. PLoS ONE 2015, 10, e0118557. [Google Scholar] [CrossRef]
- Melo, L.D.R.; Sillankorva, S.; Ackermann, H.-W.; Kropinski, A.M.; Azeredo, J.; Cerca, N. Isolation and characterization of a new Staphylococcus epidermidis broad-spectrum bacteriophage. J. Gen. Virol. 2014, 95, 506–515. [Google Scholar] [CrossRef]
- Balcão, V.M.; Vila, M.M.D.C. Structural and functional stabilization of protein entities: State-of-the-art. Adv. Drug Deliv. Rev. 2015, 93, 25–41. [Google Scholar] [CrossRef]
- Campos, W.F.; Silva, E.C.; Oliveira, T.J.; Oliveira, J.M., Jr.; Tubino, M.; Pereira, C.; Vila, M.M.D.C.; Balcão, V.M. Transdermal permeation of bacteriophage particles by choline oleate: Potential for treatment of soft-tissue infections. Future Microbiol. 2020, 15. [Google Scholar] [CrossRef]
- Silva, E.C.; Oliveira, T.J.; Moreli, F.C.; Harada, L.K.; Vila, M.M.D.C.; Balcão, V.M. Newly isolated lytic bacteriophages for Staphylococcus intermedius, structurally and functionally stabilized in a hydroxyethylcellulose gel containing choline geranate: Potential for transdermal permeation in veterinary phage therapy. Res. Vet. Sci. 2020. [Google Scholar] [CrossRef]
- Troll, W. The reaction of naphthoquinone-4-sulfonate with imino acids. J. Biol. Chem. 1953, 202, 479–486. [Google Scholar] [CrossRef]
- Thonemann, P.C.; Evans, C.J. The dispersal of an initial concentration of motile bacteria. J. Gen. Microbiol. 1976, 92, 25–31. [Google Scholar] [CrossRef] [PubMed]
- Liu, C.-H.; Wu, J.-Y.; Chang, J.-S. Diffusion characteristics and controlled release of bacterial fertilizers from modified calcium alginate capsules. Bioresour. Technol. 2008, 99, 1904–1910. [Google Scholar] [CrossRef]
- Burke, M.D.; Park, J.O.; Srinivasarao, M.; Khan, S.A. A novel enzymatic technique for limiting drug mobility in a hydrogel matrix. J. Control. Release 2005, 104, 141–153. [Google Scholar] [CrossRef]
- Wu, M.; Roberts, J.W.; Kim, S.; Koch, D.L.; DeLisa, M.P. Collective bacterial dynamics revealed using a three-dimensional population-scale defocused particle tracking technique. Appl. Environ. Microbiol. 2006, 72, 4987–4994. [Google Scholar] [CrossRef]
- Storms, Z.J.; Sauvageau, D. Modeling tailed bacteriophage adsorption: Insight into mechanisms. Virology 2015, 485, 355–362. [Google Scholar] [CrossRef]
- Dąbrowska, K.; Switala-Jelen, K.; Opolski, A.; Weber-Dabrowska, B.; Gorski, A. Bacteriophage penetration in vertebrates. J. Appl. Microbiol. 2005, 98, 7–13. [Google Scholar] [CrossRef]
- Knoll, F.G. Radiation Detection and Measurement, 4th ed.; Wiley: Hoboken, NJ, USA, 2010; ISBN 978-0-470-13148-0. [Google Scholar]
- Arduino Arduino. Available online: www.arduino.cc (accessed on 20 August 2009).

| Component | Bio-Detection System I | Bio-Detection System II | |||
|---|---|---|---|---|---|
| Formulation 1 | Formulation 2 | Formulation 3 | Formulation 4 | Formulation 5 | |
| Phage cocktail [% (w/w), m (mg)] | 0.0045; 0.045 (45 µL) | 0.0045; 0.045 (45 µL) | 0.0045; 0.045 (45 µL) | 0.050; 0.150 (150 µL) | 0.050; 0.150 (150 µL) |
| Methylparaben [% (w/w), m (mg)] | 0.000966; 0.0966 | 0.000968; 0.0968 | 0.000969; 0.0969 | 0.0010; 0.0300 | 0.0010; 0.0300 |
| Sodium alginate [% (w/w), m (mg)] | 1.50; 150 | 1.50; 150 | 1.50; 150 | 1.50; 45.00 | 1.50; 45.00 |
| CaCO3 22.5 mM [% (w/w), m (mg)] | 0.2250; 22.50 | 0.2250; 22.50 | 0.2250; 22.50 | 0.2233; 6.700 | 0.2233; 6.700 |
| GDL 48 mM [% (w/w), m (mg)] | 0.8600; 86.00 | 0.8600; 86.00 | 0.8600; 86.00 | 0.8600; 25.80 | 0.8600; 25.80 |
| Casein [% (w/w), m (mg)] | 0.1000; 10.0 | 0.0500; 5.00 | 0.0100; 1.00 | - | - |
| Gelatin [% (w/w), m (mg)] | 0.1000; 10.0 | 0.0500; 5.00 | 0.0100; 1.00 | - | - |
| Sodium 1,2-naftoquinone-4-sulfonate [% (w/w), m (mg)] | 0.1300; 13.0 | 0.0130; 1.30 | 0.0100; 1.00 | - | - |
| Luciferin [% (w/w), m (mg)] | - | - | - | 0.1667; 5.00 | 0.1667; 5.00 |
| Luciferase [% (w/w), m (mg)] | - | - | - | 0.1667; 5.00 | 0.3333; 10.0 |
| ADP [% (w/w), m (mg)] | - | - | - | 0.00006667; 0.002 | 0.0003333; 0.010 |
| Mg2+ [% (w/w), m (mg)] | - | - | - | 0.00006667; 0.002 | 0.0006667; 0.020 |
| Ultrapure water [% (w/w), m (mg)] | 97.08; 9708 | 97.30; 9730 | 97.38; 9738 | 97.10; 2913 | 96.93; 2908 |
| TOTAL [% (w/w), m (mg)] | 100; 10000 | 100; 10000 | 100; 10000 | 100; 3000 | 100; 3000 |
| Parameter | Bioluminescent/Chromogenic Hydrogel Morphological Analysis | |
|---|---|---|
| Bi-Dimensional (2D) | Three-Dimensional (3D) | |
| Number of layers | - | 101.000 |
| Pixel size (µm) | 9.7610 | 9.7610 |
| Total VOI (volume of interest), TV (mm3) | 6.8340 | 6.8292 |
| Object volume, Obj.V (mm3) | 3.55432 | 3.4115 |
| Percent object volume, Obj.V/TV (%) | 52.0094 | 49.9542 |
| Total VOI surface, TS (mm2) | 28.2910 | 27.6702 |
| Object surface, Obj.S (mm2) | 432.0516 | 377.5217 |
| Intersection surface, i.S (mm2) | - | 7.5075 |
| Object surface/volume ratio, Obj.S/Obj.V (mm−1) | 121.5566 | 110.6616 |
| Cross-sectional thickness, Cs.Th (mm) | 0.02533 | - |
| Object surface density, Obj.S/TV (mm−1) | - | 55.2802 |
| Degree of anisotropy, DA | - | 3.2631 (0.6936) |
| Eigenvalue 1 | - | 3.5861 |
| Eigenvalue 2 | - | 6.5491 |
| Eigenvalue 3 | - | 11.7020 |
| Number of closed pores, Po.N(cl) | - | 5125 |
| Volume of closed pores, Po.V(cl) (mm3) | - | 0.00472 |
| Surface of closed pores, Po.S(cl) (mm2) | - | 2.7836 |
| Closed porosity (percent), Po(cl) (%) | 6.8883 | 0.1383 |
| Mean fragmentation index, Fr.I (mm−1) | −58.7603 | −71.3382 |
| Mean fractal dimension, FD | 1.7048 | 2.6834 |
| Volume of open pore space, Po.V(op) (mm3) | - | 3.4130 |
| Open porosity (percent), Po(op) (%) | - | 49.9766 |
| Total volume of pore space, Po.V(tot) (mm3) | - | 3.4178 |
| Total porosity (percent), Po(tot) (%) | - | 50.0458 |
| Euler number, Eu.N | - | −72,773.000 |
| Connectivity, Conn | - | 83,998.000 |
| Connectivity density, Conn.Dn (mm−3) | - | 12,299.7496 |
Publisher’s Note: MDPI stays neutral with regard to jurisdictional claims in published maps and institutional affiliations. |
© 2021 by the authors. Licensee MDPI, Basel, Switzerland. This article is an open access article distributed under the terms and conditions of the Creative Commons Attribution (CC BY) license (https://creativecommons.org/licenses/by/4.0/).
Share and Cite
Harada, L.K.; Júnior, W.B.; Silva, E.C.; Oliveira, T.J.; Moreli, F.C.; Júnior, J.M.O.; Tubino, M.; Vila, M.M.D.C.; Balcão, V.M. Bacteriophage-Based Biosensing of Pseudomonas aeruginosa: An Integrated Approach for the Putative Real-Time Detection of Multi-Drug-Resistant Strains. Biosensors 2021, 11, 124. https://doi.org/10.3390/bios11040124
Harada LK, Júnior WB, Silva EC, Oliveira TJ, Moreli FC, Júnior JMO, Tubino M, Vila MMDC, Balcão VM. Bacteriophage-Based Biosensing of Pseudomonas aeruginosa: An Integrated Approach for the Putative Real-Time Detection of Multi-Drug-Resistant Strains. Biosensors. 2021; 11(4):124. https://doi.org/10.3390/bios11040124
Chicago/Turabian StyleHarada, Liliam K., Waldemar Bonventi Júnior, Erica C. Silva, Thais J. Oliveira, Fernanda C. Moreli, José M. Oliveira Júnior, Matthieu Tubino, Marta M. D. C. Vila, and Victor M. Balcão. 2021. "Bacteriophage-Based Biosensing of Pseudomonas aeruginosa: An Integrated Approach for the Putative Real-Time Detection of Multi-Drug-Resistant Strains" Biosensors 11, no. 4: 124. https://doi.org/10.3390/bios11040124
APA StyleHarada, L. K., Júnior, W. B., Silva, E. C., Oliveira, T. J., Moreli, F. C., Júnior, J. M. O., Tubino, M., Vila, M. M. D. C., & Balcão, V. M. (2021). Bacteriophage-Based Biosensing of Pseudomonas aeruginosa: An Integrated Approach for the Putative Real-Time Detection of Multi-Drug-Resistant Strains. Biosensors, 11(4), 124. https://doi.org/10.3390/bios11040124

